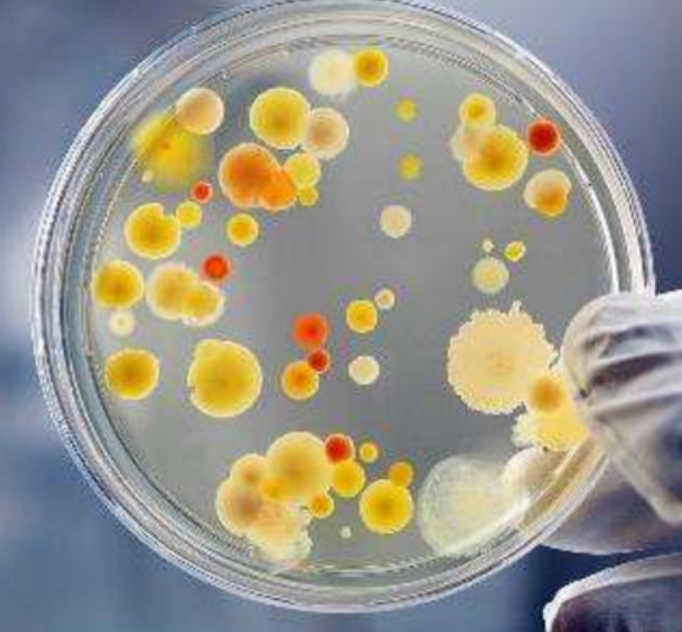
产品细节图片1

万千商家帮你免费找货
0 人在求购买到急需产品
- 详细信息
- 文献和实验
- 技术资料
- 提供商:
上海达为科生物科技有限公司
- 服务名称:
细胞分选服务
| 品牌 | 其他品牌 | 产地类别 | 国产 |
|---|---|---|---|
| 应用领域 | 医疗卫生,生物产业,综合 |
细胞分选服务:是指据细胞的属性,讲混合的细胞分为不同特性的几个不同类群的方法,本公司运用的是免疫磁珠细胞分选。
细胞分选服务是达为科生物的项目组成之一,该项目实验由经验丰富的人员进行操作。
公司位于上海长江软件园,目前具备较好的的生物学、医学技术服务平台,能够为广大客户提供医学科研样本检测、合作研究、开发及生产服务。且具备从上游的高通量筛选到下游特定基因功能解析的完善整合技术平台,能够真正为客户提供专业、完善的技术解决方案和服务,我们拥有专业的实验室、先进的实验设备和经验丰富的科研技术人员。技术团队包括研究员(博士后)2人,助理研究员(博士)4人,核心研究员(硕士)15人,主要致力于基因组学、转录组学、蛋白质组学、代谢组学、生物化学、病理检测、基因检测等技术在科研中的应用与推广。通过高度细分、较好的的服务平台,为广大客户提供了完善的技术解决方案和服务。 更为可喜的是,公司于2015年投资建立了1800平方米的动物中心,能够为广大客户提供更为专业的实验动物饲养及造模服务。
风险提示:丁香通仅作为第三方平台,为商家信息发布提供平台空间。用户咨询产品时请注意保护个人信息及财产安全,合理判断,谨慎选购商品,商家和用户对交易行为负责。对于医疗器械类产品,请先查证核实企业经营资质和医疗器械产品注册证情况。
 文献和实验
文献和实验磁性细胞分选(MACS)是一种20世纪70年代发展起来的相对高效简便的细胞分选方法,所需设备和操作较为简单,对操作人员的技术要求也不高,只是让细胞处于一个低磁场中,基本可以忽略对细胞的影响,分离得到的细胞具有较高的复苏率及细胞活性,对于下游应用影响较小,在保持细胞活性方面优于流式分选,是细胞分选的首选方法,具有潜在的应用前景。 1 磁性细胞分选原理 磁性细胞分选是基于免疫学中抗原抗体之间特异性结合的原理进行的。以磁性微粒作为载体,对其进行抗体或亲和配体包被,形成免疫磁性复合微粒
MACSQuant Tyto 细胞分选仪助力开发 COVID-19 新疗法
患者。在医院里,我们更接近了病人:我们得到了患者的实际样本,并直接与他们合作。因为我们如此接近患者与疾病,同时致力于如何治愈它;这种与病人和医生的亲密关系——不仅激励我们继续应对挑战,更是实时地看到我们所做的改变,可对患者有所助益。 MACSQuant® Tyto®细胞分选仪基于世界上最快的阀门开合的分选技术,不产生气溶胶和释放任何液滴。 2.你主要使用 MACSQuant® Tyto® 细胞分选仪来分选B细胞吗? 对。当这个仪器为我们演示时,我们实际上计划使用
细胞 其他 EasySep® EasySep 快速 :最快在20分钟内完成细胞分选 简单温和 :无须分离柱,无须洗涤步骤 高纯度 :最高可达99%纯度 EasySep® MultistandMultistand 可容纳达至四个EasySep® (Catalog #18000 和#18001) 磁铁。 更多了解请点击 EasySep® RoboSep® 全自动细胞分选仪器 样本处理过程减到最低 :由机器完成细胞分选过程中所有步骤,减少工作人员对病毒的接触











